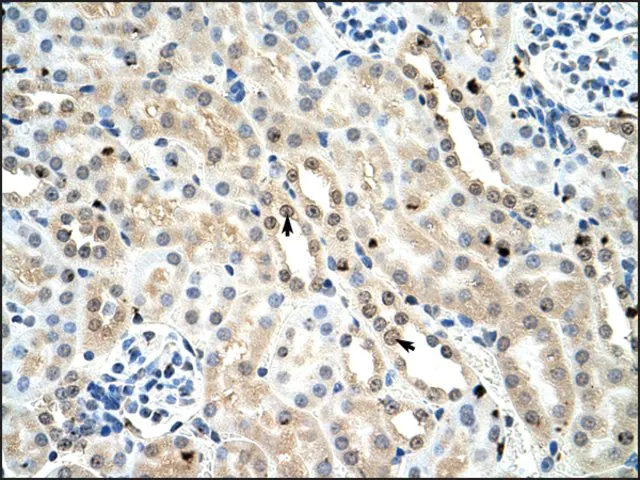

您的位置:首页 > 半岛bd体育手机客户端
中心 > Anti-FOXK1 antibody produced in rabbit
Anti-FOXK1 antibody produced in rabbit
| 半岛bd体育手机客户端 编号: | 3363126 |
| 规格: | IgG fraction of antiserum |
| 包装规格: | 100 μL |
| 半岛bd体育手机客户端 类别: | 进口试剂 |
| 品牌: | Sigma-Aldrich |
| 优惠价: | 立即咨询 |
半岛bd体育手机客户端
性质
| biological source【生物来源】 | rabbit |
| Quality Level【质量水平】 | 100 |
| conjugate【偶联物】 | unconjugated |
| antibody form【抗体形式】 | IgG fraction of antiserum |
| antibody product type | primary antibodies |
| clone【克隆】 | polyclonal |
| form【形式】 | buffered aqueous solution |
| mol wt【分子量】 | 68 kDa |
| species reactivity | human, mouse |
| concentration【浓度】 | 0.5 mg - 1 mg/mL |
| technique(s) | immunohistochemistry: suitable western blot: suitable |
| NCBI accession no.【NCBI登记号】 | NP_951031 |
| UniProt accession no.【UniProt登记号】 | P42128 |
| shipped in【运输】 | wet ice |
| storage temp.【储存温度】 | −20℃ |
| Gene Information | mouse ... FOXK1(17425) |
基本信息
| Immunogen【免疫原】 | Synthetic peptide directed towards the C terminal region of mouse FOXK1 |
| Biochem/physiol Actions【生化/生理作用】 | Foxk1 is a transcriptional regulator that binds to the upstream enhancer region (CCAC box) of myoglobin gene. It has a role in myogenic differentiation and in remodeling processes of adult muscles that occur in response to physiological stimuli. |
| Sequence【序列】 | Synthetic peptide located within the following region: VVQQAPTVTMVRVVTTSANSANGYILASQGSTGTSHDTAGTAVLDLGNEA |
| Physical form【外形】 | Purified antibody supplied in 1x PBS buffer with 0.09% (w/v) sodium azide and 2% sucrose. |
半岛bd体育手机客户端
说明
| Disclaimer【免责声明】 | Unless otherwise stated in our catalog or other company documentation accompanying the product(s), our products are intended for research use only and are not to be used for any other purpose, which includes but is not limited to, unauthorized commercial uses, in vitro diagnostic uses, ex vivo or in vivo therapeutic uses or any type of consumption or application to humans or animals. |
安全信息
| Storage Class Code【储存分类代码】 | 12 - Non Combustible Liquids |
| WGK | WGK 1 |





